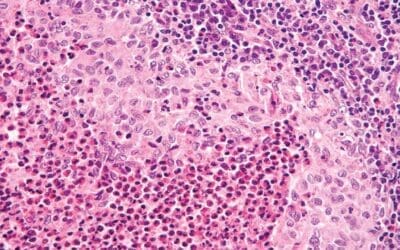
Langerhans Cell Histiocytosis (Histiocytosis X)

Key Takeaways
The plasma cell is the terminal, non-proliferating B-lymphocyte dedicated to antibody secretion. Plasma cells originate from B-cells via the Germinal Center (GC) reaction in lymphoid organs.
- Morphology ▾: Plasma cells has an eccentric nucleus with characteristic “spoke-wheel” chromatin, a deeply basophilic cytoplasm packed with Rough Endoplasmic Reticulum (rER), and a prominent pale perinuclear clear zone (Hof) representing the active Golgi apparatus.
- Plasma cell disorders ▾: Plasmacyte Dyscrasias are caused by clonal expansion, leading to a single abnormal Monoclonal Protein (M-protein). They include MGUS, multiple myeloma, AL amyloidosis and others.
*Click ▾ for more information
Introduction
Plasma cells represent the terminally differentiated stage of B lymphocytes, serving as the body’s dedicated factories for antibody production. Their essential role in humoral immunity, providing long-term protective memory, contrasts sharply with their pathological potential as the malignant clone in plasma cell dyscrasias like multiple myeloma (MM). Understanding the biology of normal plasma cells differentiation and survival is fundamental in grasping the pathophysiology and targeted treatment of these hematological malignancies.
Plasma Cell Origin and Development
A plasma cell (or plasmacyte) is the terminally differentiated, non-proliferating effector cell of the B-lymphocyte lineage. Its sole purpose is the mass production and secretion of highly specific antibodies (immunoglobulins). Once fully differentiated, it ceases to display the B-cell receptor (BCR) on its surface and dedicates its enormous internal machinery to protein synthesis.
Plasma cells arise primarily within the germinal centers (GCs) of secondary lymphoid organs (e.g., lymph nodes, spleen), following antigen presentation and T-cell-dependent activation. This differentiation process is a tightly regulated sequence of cellular and genetic changes that culminates in a potent antibody-secreting machine.
Key Stages of Differentiation

Initial Activation of Naive B-Cells
The differentiation begins when a naive B-cell encounters its specific antigen in a lymphoid follicle.
- Antigen Capture: The B-cell uses its surface-bound immunoglobulin (B-Cell Receptor or BCR, typically IgM or IgD) to bind the antigen.
- Antigen Processing: The B-cell internalizes the antigen, processes it, and presents antigenic peptides on its surface via MHC Class II molecules.
T-Cell Help and Germinal Center Formation
For most high-affinity, long-lasting antibody responses (T-dependent antigens), B-cell differentiation requires help from T helper cells (specifically Follicular Helper T cells, Tfh).
- Cognate Interaction: The activated B-cell migrates to the T-cell zone, where it interacts with a Tfh cell. The Tfh cell recognizes the same antigen peptide presented by the B-cell’s MHC Class II.
- Co-stimulation: The Tfh cell provides vital co-stimulatory signals (e.g., CD40L binding to CD40 on the B-cell) and secretes specific cytokines. These signals drive the B-cell to rapidly proliferate, forming a temporary, highly specialized structure called the Germinal Center (GC) within the lymphoid follicle.
Affinity Maturation (Somatic Hypermutation) and Class Switching
Inside the Germinal Center, B cells undergo two critical processes that refine and empower the immune response:
- Somatic Hypermutation (SHM): B-cells rapidly proliferate and their Ig-variable region genes undergo point mutations. This leads to B-cells with slightly varying BCR affinities. Only those cells with high-affinity receptors (tested against the antigen by Follicular Dendritic Cells, or FDCs) are selected to survive and continue differentiating. This process is called Affinity Maturation.
- Class Switch Recombination (CSR): Driven by cytokines from the Tfh cell, B-cells switch the heavy chain constant region of their antibody, moving from producing IgM/IgD to producing IgG, IgA, or IgE, which are tailored for specific effector functions and sites (e.g., IgA for mucosal immunity).
Terminal Differentiation into Plasma Cells
The selected and refined B-cells exit the Germinal Center and commit to terminal differentiation, driven by transcription factors like Blimp-1 (B-lymphocyte-induced maturation protein-1), which represses B-cell gene expression and activates plasma cell programs.
- Plasmablasts: These are short-lived, still-dividing cells that secrete antibodies rapidly and often migrate immediately out of the lymphoid tissue to respond to an acute infection.
- Long-Lived Plasma Cells (LLPCs): The most critical population for long-term immunity. They migrate primarily to specialized bone marrow niches, where they can survive for years or decades, continuously secreting protective, high-affinity antibodies (primarily IgG). This sustained output provides the foundation for immunological memory and permanent protection against re-infection.
Location
While the differentiation starts in secondary lymphoid organs, mature plasma cells are primarily found in locations that maximize their function:
- Bone Marrow: The main site for long-lived plasma cell residency.
- Spleen and Lymph Nodes: Contain both recently generated plasmablasts and some short-lived plasma cells.
- Mucosal Tissues (e.g., GI tract, respiratory tract): Key sites for IgA-secreting plasma cells, which provide mucosal immunity.
Morphology and Phenotype of Plasma Cell

The plasma cell’s unique appearance is directly linked to its function: the high-volume, continuous synthesis and secretion of antibodies. On a standard hematoxylin and eosin (H&E) stain or Wright-Giemsa stain (commonly used in hematology), these cells exhibit several hallmark features that distinguish them from other immune cells.
Size and Shape
Plasma cells are relatively large, typically measuring 10 to 20 µm in diameter, which is significantly larger than a small lymphocyte. They possess a characteristic ovoid or teardrop shape.
Nucleus
The nucleus of a plasma cell is arguably its most recognizable feature under light microscopy:
- Eccentric Position: The nucleus is pushed distinctly to one side or pole of the cell, giving the cell an asymmetrical appearance. This displacement is caused by the massive expansion of the cytoplasm by the protein-synthesizing machinery (the Golgi and rER).
- “Spoke-Wheel” or “Clock-Face” Chromatin: The chromatin is coarsely clumped and arranged in radial segments around the inner edge of the nuclear membrane. When viewed under the light microscope, this pattern resembles the spokes of a wheel or the numbers on a clock face. This pattern indicates that the DNA is relatively condensed (heterochromatin), as the cell is terminally differentiated and not actively dividing.
Cytoplasm (Light Microscopy)
The cytoplasmic features are a direct reflection of its secretory function:
- Deep Basophilia: The cytoplasm stains intensely blue-purple (basophilic). This is due to the extremely high concentration of ribonucleic acid (RNA) associated with the numerous ribosomes found in the rough endoplasmic reticulum (rER). The RNA avidly binds the basic component of the stain.
- Perinuclear Clear Zone (Hof): Adjacent to the eccentric nucleus is a prominent, pale-staining area. This Hof (meaning “clear zone”) represents the location of the highly developed, active Golgi Apparatus and the centrosome. The Golgi is responsible for the post-translational modification, sorting, and packaging of the newly synthesized antibodies before they are secreted.
Ultrastructure (Electron Microscopy)
Under electron microscopy, the cell’s specialization becomes even clearer:
- Abundant Rough Endoplasmic Reticulum (rER): This is the ultimate defining feature of the plasma cell. The cytoplasm is virtually filled with parallel, stacked cisternae of rER, which are studded with millions of ribosomes. This massive network functions as the assembly line for antibody synthesis.
- Mitochondria: Numerous mitochondria are present to provide the massive energy (ATP) required to drive the synthesis, modification, and secretion of antibodies, which occurs at a rate of several thousand molecules per second per cell.
Immunophenotype
PCs shed or significantly downregulate common B-cell markers and acquire unique surface markers:
- Loss/Low Expression: CD19, CD20, sIg (surface immunoglobulin).
- Acquired/High Expression: CD38 (very high), CD138 (Syndecan-1), CD27, and intracellular Ig.
Lifespan and Physiological Range
Lifespan and Survival Strategy (Kinetics)
The plasma cell population is not uniform; it consists of two distinct functional pools with vastly different lifespans.
Short-Lived Plasma Cells (Plasmablasts)
- Origin and Location: These cells exit the secondary lymphoid organs (SLOs) shortly after activation, often bypassing the full germinal center reaction, especially during T-independent responses or early primary responses. They are found circulating in the peripheral blood and residing briefly in lymphoid tissues.
- Function: They provide an immediate, rapid burst of antibody production, often involving IgM (the first class produced).
- Lifespan: Their duration is short, typically lasting only a few days to a couple of weeks. They undergo apoptosis (programmed cell death) once the acute phase of infection is controlled and the associated inflammatory signals diminish.
Long-Lived Plasma Cells (LLPCs)
- Origin and Location: These are the most critical components of immunological memory, derived from high-affinity B-cells that successfully navigated the germinal center reaction and class switching. They migrate out of the SLOs and establish residence primarily within the Bone Marrow (BM), and to a lesser extent, in the spleen and mucosal lamina propria.
- Function: They continuously secrete high-affinity antibodies, usually IgG or IgA, maintaining protective antibody titers long after the initial infection has cleared.
- Lifespan: They are functionally immortal, capable of surviving for years or even the lifetime of the host. This longevity forms the basis of persistent immunity conferred by vaccinations and childhood infections.
- The Bone Marrow Niche: LLPCs survive in the bone marrow due to a specialized microenvironment known as the plasma cell survival niche. Key components of this niche include:
- Stromal Cells: Provide physical support and direct contact signals.
- Survival Cytokines: Continuous production of factors like IL-6 (Interleukin-6) and APRIL (A Proliferation-Inducing Ligand), which prevent apoptosis and maintain the cell’s secretory function.
Physiological Reference Range
The normal reference range for plasma cells is extremely tightly controlled, making their presence or increased number a highly sensitive clinical marker.
| Location | Normal Range | Clinical Significance of Exceeding Range |
| Peripheral Blood | Normally Absent or Extremely Rare | Presence may indicate an active acute infection (circulating plasmablasts) or, more critically, a lymphoproliferative or plasma cell disorder (e.g., plasma cell leukemia). |
| Bone Marrow | Typically less than 5% of all nucleated cells | A percentage exceeding 10% of nucleated cells in a bone marrow biopsy is highly suspicious for a Plasma Cell Dyscrasia (such as Multiple Myeloma), especially if the cells are clonal. |
The low percentage in the bone marrow confirms that plasma cells are effector cells, not proliferative cells; their commitment to antibody production means their quantity is closely monitored by the body to avoid autoimmune or excessive immune responses.
The Plasma Cell Primary Function
The plasma cell is the terminally committed effector of humoral immunity, responsible for the mass production and secretion of specific antibodies. It is essentially an “antibody factory,” sacrificing the ability to divide (non-proliferative) and present antigen (loss of MHC Class II) for maximum secretory output.
The Effector Role: Dedicated Antibody Factory
Plasma cells maintain a sustained output, secreting antibodies at an astonishing rate, estimated to be several thousand molecules per second per cell. These secreted antibodies are known as immunoglobulins (Ig), and they circulate in the blood and lymph, or are transferred across epithelial surfaces (e.g., IgA) to provide protection.
Mechanism of Antibody Synthesis and Secretion
The plasma cell morphology perfectly illustrates its function:
- Transcription and Translation: The genetic instructions for the specific antibody (refined through somatic hypermutation and class switching in the germinal center) are transcribed into mRNA. This mRNA is translated into heavy and light polypeptide chains on the ribosomes studding the massive network of Rough Endoplasmic Reticulum (rER).
- Assembly and Glycosylation: Within the cisternae of the rER, the heavy and light chains assemble into the complete antibody structure. Initial protein folding and post-translational modifications (like glycosylation) occur here.
- Packaging and Sorting: Antibodies are transported to the prominent Golgi Apparatus (the perinuclear clear zone or Hof). Here, they undergo final maturation, sorting, and packaging into secretory vesicles.
- Secretion: The secretory vesicles move to the cell membrane, fuse with it, and release the antibodies into the extracellular space (blood, lymph, or mucosal fluid) via exocytosis.
In disorders like Multiple Myeloma, the clonal plasma cells produce an excessive amount of a single, structurally identical antibody. This excess, detectable in the blood or urine, is referred to as a Monoclonal Protein (M-protein) or paraprotein.
Humoral Immunity: The Effector Functions of Antibodies
Once secreted, the antibodies perform the functions necessary to clear the antigen.
| Function | Mechanism |
| Neutralization | Antibodies physically bind to microbial surfaces (e.g., viral envelopes, bacterial toxins), preventing them from interacting with or entering host cells. This is the primary defense against toxins and viruses. |
| Opsonization | Antibodies (particularly IgG) coat a pathogen. Phagocytic cells (like macrophages and neutrophils) possess receptors (Fcγ Receptors) that recognize the Fc (constant) region of the bound antibody, enhancing the efficiency of phagocytosis. |
| Complement Activation | Bound antibodies (chiefly IgM and two IgG molecules) initiate the classical pathway of the complement cascade. This leads to the formation of the Membrane Attack Complex (MAC), which punches holes in the pathogen’s membrane, causing lysis. |
| Antibody-Dependent Cell-mediated Cytotoxicity (ADCC) | Antibodies bind to an infected or abnormal cell. Natural Killer (NK) cells then bind the Fc region of these antibodies via their Fc receptors and induce the target cell to undergo apoptosis. |
Immunological Memory and Sustained Protection
The Long-Lived Plasma Cells (LLPCs) residing in the bone marrow are the physical embodiment of immunological memory. Unlike memory B-cells, which require re-stimulation to differentiate, LLPCs are constantly generating high-affinity antibodies. This continuous, low-level secretion ensures that the body maintains a protective basal antibody titer, providing immediate defense upon secondary exposure to a previously encountered pathogen.
Plasma Cell Dyscrasias (PCDs)
Plasma Cell Disorders (or plasmacyte dyscrasias) represent a spectrum of conditions characterized by the clonal expansion of plasma cells in the bone marrow or other sites. This clonal expansion results in the excessive production and secretion of a single, structurally identical immunoglobulin or immunoglobulin subunit. This abnormal protein is referred to as a Monoclonal Protein (M-protein) or paraprotein.
The disorders range from benign, asymptomatic conditions requiring only observation to aggressive, disseminated malignancies.
Monoclonal Gammopathy of Undetermined Significance (MGUS)
MGUS is the most common and least severe of the plasma cell dyscrasias. It is defined by the presence of a serum M-protein (paraprotein) without evidence of end-organ damage (no CRAB criteria).
- Clonal Plasma Cells: Less than 10% of nucleated cells in the bone marrow are clonal plasma cells.
- M-protein Level: Serum M-protein concentration is less than 30 g/L.
MGUS is considered a pre-malignant condition. While asymptomatic, it carries a small but persistent risk (approximately 1% per year) of progressing to a symptomatic disorder, most commonly Multiple Myeloma. Patients with MGUS are typically monitored with regular blood tests but do not require treatment.
Multiple Myeloma (MM)
Multiple Myeloma (MM) is a malignant plasma cell neoplasm characterized by the proliferation of clonal plasma cells in the bone marrow, leading to skeletal destruction and failure of normal hematopoiesis.
- Clonal Plasma Cells: 10% or more clonal plasma cells in the bone marrow OR biopsy-proven plasmacytoma AND evidence of related end-organ damage.
- M-protein: High levels of M-protein (e.g., IgG or IgA) are typically present in the serum and/or urine (Bence Jones protein).
The diagnosis of symptomatic MM requires the presence of an M-protein and one or more of the following myeloma-defining events (historically known as the CRAB criteria):
- HyperCalcemia: Serum calcium level greater than 0.25 mmol/L above the upper limit of normal or > 2.75 mmol/L. This results from bone destruction caused by the myeloma cells releasing osteoclast-activating factors.
- Renal Impairment: Creatinine clearance < 40 mL/min or a serum creatinine level > 177 µmol/L (renal failure). This is primarily due to the toxic effect of light chains (Bence Jones proteins) on the renal tubules (myeloma kidney).
- Anemia: Hemoglobin level < 100 g/L or 20 g/L below the lower limit of normal. This is due to the malignant plasma cells crowding out and inhibiting normal red blood cell production in the bone marrow.
- Bone Lesions: One or more lytic lesions on skeletal radiography, CT, or PET-CT scans. These are areas of bone destruction without evidence of repair.
Solitary Plasmacytoma
A localized tumor mass composed of clonal plasma cells. It is classified based on location.
- Solitary Bone Plasmacytoma (SBP): A single lytic lesion in the bone without systemic involvement (CRAB criteria absent).
- Extramedullary Plasmacytoma (EMP): A plasma cell tumor arising outside the bone marrow, most commonly in the upper respiratory tract.
Both conditions require regular follow-up due to the risk of progression to MM.
Primary Amyloidosis (AL Amyloidosis)
This is a disorder where a clone of plasma cells produces excess amounts of immunoglobulin light chains (usually Lambda type). These light chains are unstable and misfold, depositing as insoluble beta-pleated sheets of protein (amyloid fibrils) in various organs (e.g., heart, kidney, liver, nervous system). Organ dysfunction is caused by the physical deposition of the amyloid protein, not bone marrow replacement.
Waldenström’s Macroglobulinemia (WM)
WM is a rare, indolent (slow-growing) lymphoplasmacytic lymphoma that involves the overproduction of clonal IgM antibodies.
The excessive IgM is a large pentameric molecule that dramatically increases blood viscosity, leading to symptoms of hyperviscosity syndrome (e.g., blurred vision, headache, bleeding).
Monitoring and Treatment Principles
The management of PCDs relies heavily on accurately quantifying the M-protein (using serum protein electrophoresis and immunofixation) and the involved/uninvolved free light chains.
Current MM treatment is risk-adapted and typically involves a combination of three or four agents targeting the plasma cells and its microenvironment.
- Proteasome Inhibitors (PIs): E.g., Bortezomib, Carfilzomib. These block the proteasome, causing toxic protein accumulation and apoptosis in plasma cells, which are high-volume protein (antibody) secretors.
- Immunomodulatory Drugs (IMiDs): E.g., Lenalidomide, Pomalidomide. These have anti-myeloma, anti-angiogenic, and immunomodulatory effects.
- Monoclonal Antibodies: E.g., Daratumumab (anti-CD38), Elotuzumab (anti-SLAMF7). These target surface antigens highly expressed on plasma cells.
- Autologous Stem Cell Transplantation (ASCT): Remains a standard consolidation approach for eligible, transplant-fit patients.
Frequently Asked Questions (FAQs)
How does the plasma cell’s structure relate to its function?
The plasma cell is structurally optimized for high-volume protein secretion. Its defining feature is the dramatic increase in the size and organization of the rough endoplasmic reticulum (RER) and Golgi apparatus, which are essential organelles for synthesizing, folding, and secreting the large quantities of antibody proteins.
Why do plasma cell disorders cause bone damage?
Malignant plasma cells hijack the normal bone remodeling process in the bone marrow microenvironment. They secrete pro-osteoclastic factors, notably MIP-1α and RANKL, which stimulate the bone-resorbing cells (osteoclasts) to become hyperactive. They also secrete factors like DKK1 that inhibit bone-forming cells (osteoblasts). This imbalance leads to net bone destruction, causing lytic lesions, bone pain, and hypercalcemia.
What is the clinical difference between MGUS and Smoldering Multiple Myeloma (SMM)?
Both are asymptomatic precursor conditions. MGUS is defined by a low burden of clonal cells and M-protein, with a low, constant risk of progression (approx. 1%/year). SMM has a higher clonal burden and M-protein level, placing it closer to active MM. While SMM is traditionally treated by watchful waiting, modern guidelines identify “high-risk SMM” based on biomarkers (SLiM features) that mandate close monitoring or even therapeutic intervention due to a very high risk of progression to symptomatic MM in the short term.

Glossary of Key Medical Terms
- Monoclonal Protein (M-protein): A structurally homogeneous immunoglobulin (or Ig fragment) produced by a single, expanded clone of plasma cells.
- Humoral Immunity: Antibody-mediated immunity, based on the actions of antibodies secreted by plasma cells.
- Somatic Hypermutation (SHM): A process occurring in B cells during the germinal center reaction that introduces point mutations into the V-regions of Ig genes, refining antibody affinity.
- CD138 (Syndecan-1): A proteoglycan highly expressed on the surface of mature and malignant plasma cells, used as a key immunophenotypic marker.
- CRAB Criteria: The classic diagnostic criteria for symptomatic multiple myeloma: Calcium elevation, Renal failure, Anemia, Bone lesions.
- Blimp-1 (PRDM1): B-lymphocyte-induced maturation protein-1; the master transcription factor driving terminal B-cell differentiation into a plasma cell.
- Lytic Lesion: Areas of focal bone destruction seen in multiple myeloma, caused by myeloma cell-induced activation of osteoclasts.
Disclaimer: This article is intended for informational purposes only and is specifically targeted towards medical students. It is not intended to be a substitute for informed professional medical advice, diagnosis, or treatment. While the information presented here is derived from credible medical sources and is believed to be accurate and up-to-date, it is not guaranteed to be complete or error-free. See additional information.
References
- Allen HC, Sharma P. Histology, Plasma Cells. [Updated 2022 Dec 30]. In: StatPearls [Internet]. Treasure Island (FL): StatPearls Publishing; 2025 Jan-. Available from: https://www.ncbi.nlm.nih.gov/books/NBK556082/
- D’Souza, L., & Bhattacharya, D. (2019). Plasma cells: You are what you eat. Immunological reviews, 288(1), 161–177. https://doi.org/10.1111/imr.12732
- Morgan, H. T., Derman, B. A., Ma, H., & Kumar, S. K. (2025). Changing lanes: extending CAR T-cell therapy to high-risk plasma cell dyscrasias. Frontiers in immunology, 16, 1558275. https://doi.org/10.3389/fimmu.2025.1558275
- Gavriatopoulou, M., Fotiou, D., Ntanasis-Stathopoulos, I., Kastritis, E., Terpos, E., & Dimopoulos, M. A. (2018). How I treat elderly patients with plasma cell dyscrasias. Aging, 10(12), 4248–4268. https://doi.org/10.18632/aging.101707